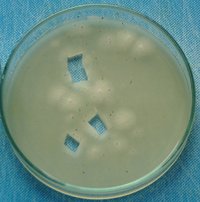

Por favor, leia com atenção as Regras e o Termo de Responsabilidade do Fórum. Ambos lhe ajudarão a entender o que esperamos em termos de conduta no Fórum e também o posicionamento legal do mesmo.
Há também na Suíça petris preesterilizado feito de plástico. Eles são para uma vez utilização e alguém esterilizado os em algum lugares esperançosamente.
Os que nós compramos são feitos de vidro, e não são preesterilizados, mas nós podemos usá-los cento vezes e sabemos com certeza como eles foram esterilizados..... acho que isto é muito melhor e mais barato naturalmente.




Será que essa placa da 1° foto está contaminada?![]()
Esporos secos são extremamentes ruins pra germinar![]()

Pode ficar tal lentamente, aquele é nada anormal.
Espere, relaxe .... e beba chá .... nós verá
Tb não em parece nada normal..
Mas acho que isso se deve ao fato de minha incubadora ( armario da cozinha ) não estar quente..
Vc me aconselharia a comprar um isopor ( stiropor )?
Porque acho que o armario da cozinha já não está mais funcionando...
E ESSE CHÁ QUE VC ME INDICOU BEBER, É CHÁ DE COGUMELOS MESMO?![]()
Sim para abaixo o petris um pouco de styropor é definitivamente bom. Você tem um termômetro? Qualquer coisa entre 23 e 30 graus estarão bom, ótimo é aproximadamente 25 a 28 graus
Que show esse tyópico eim menina, puta aula vc tá dando pra gente


























E pra que essa cerveja no receita? Qual a função?
![]()
Shanti - I like to do the Potato Dextrosis Agar recipe.(BDA here in portuguese)é uma receita usada largamente para Petris, conhecido num modo melhor como o BPA = Beer Potato Agar
A razão que F+ não foi era provável dentro a carimbo. Já a carimbo foi contaminada. Isto você pode ver da contaminação de levedura exatamente em torno aos esporos pretos sobre o petris